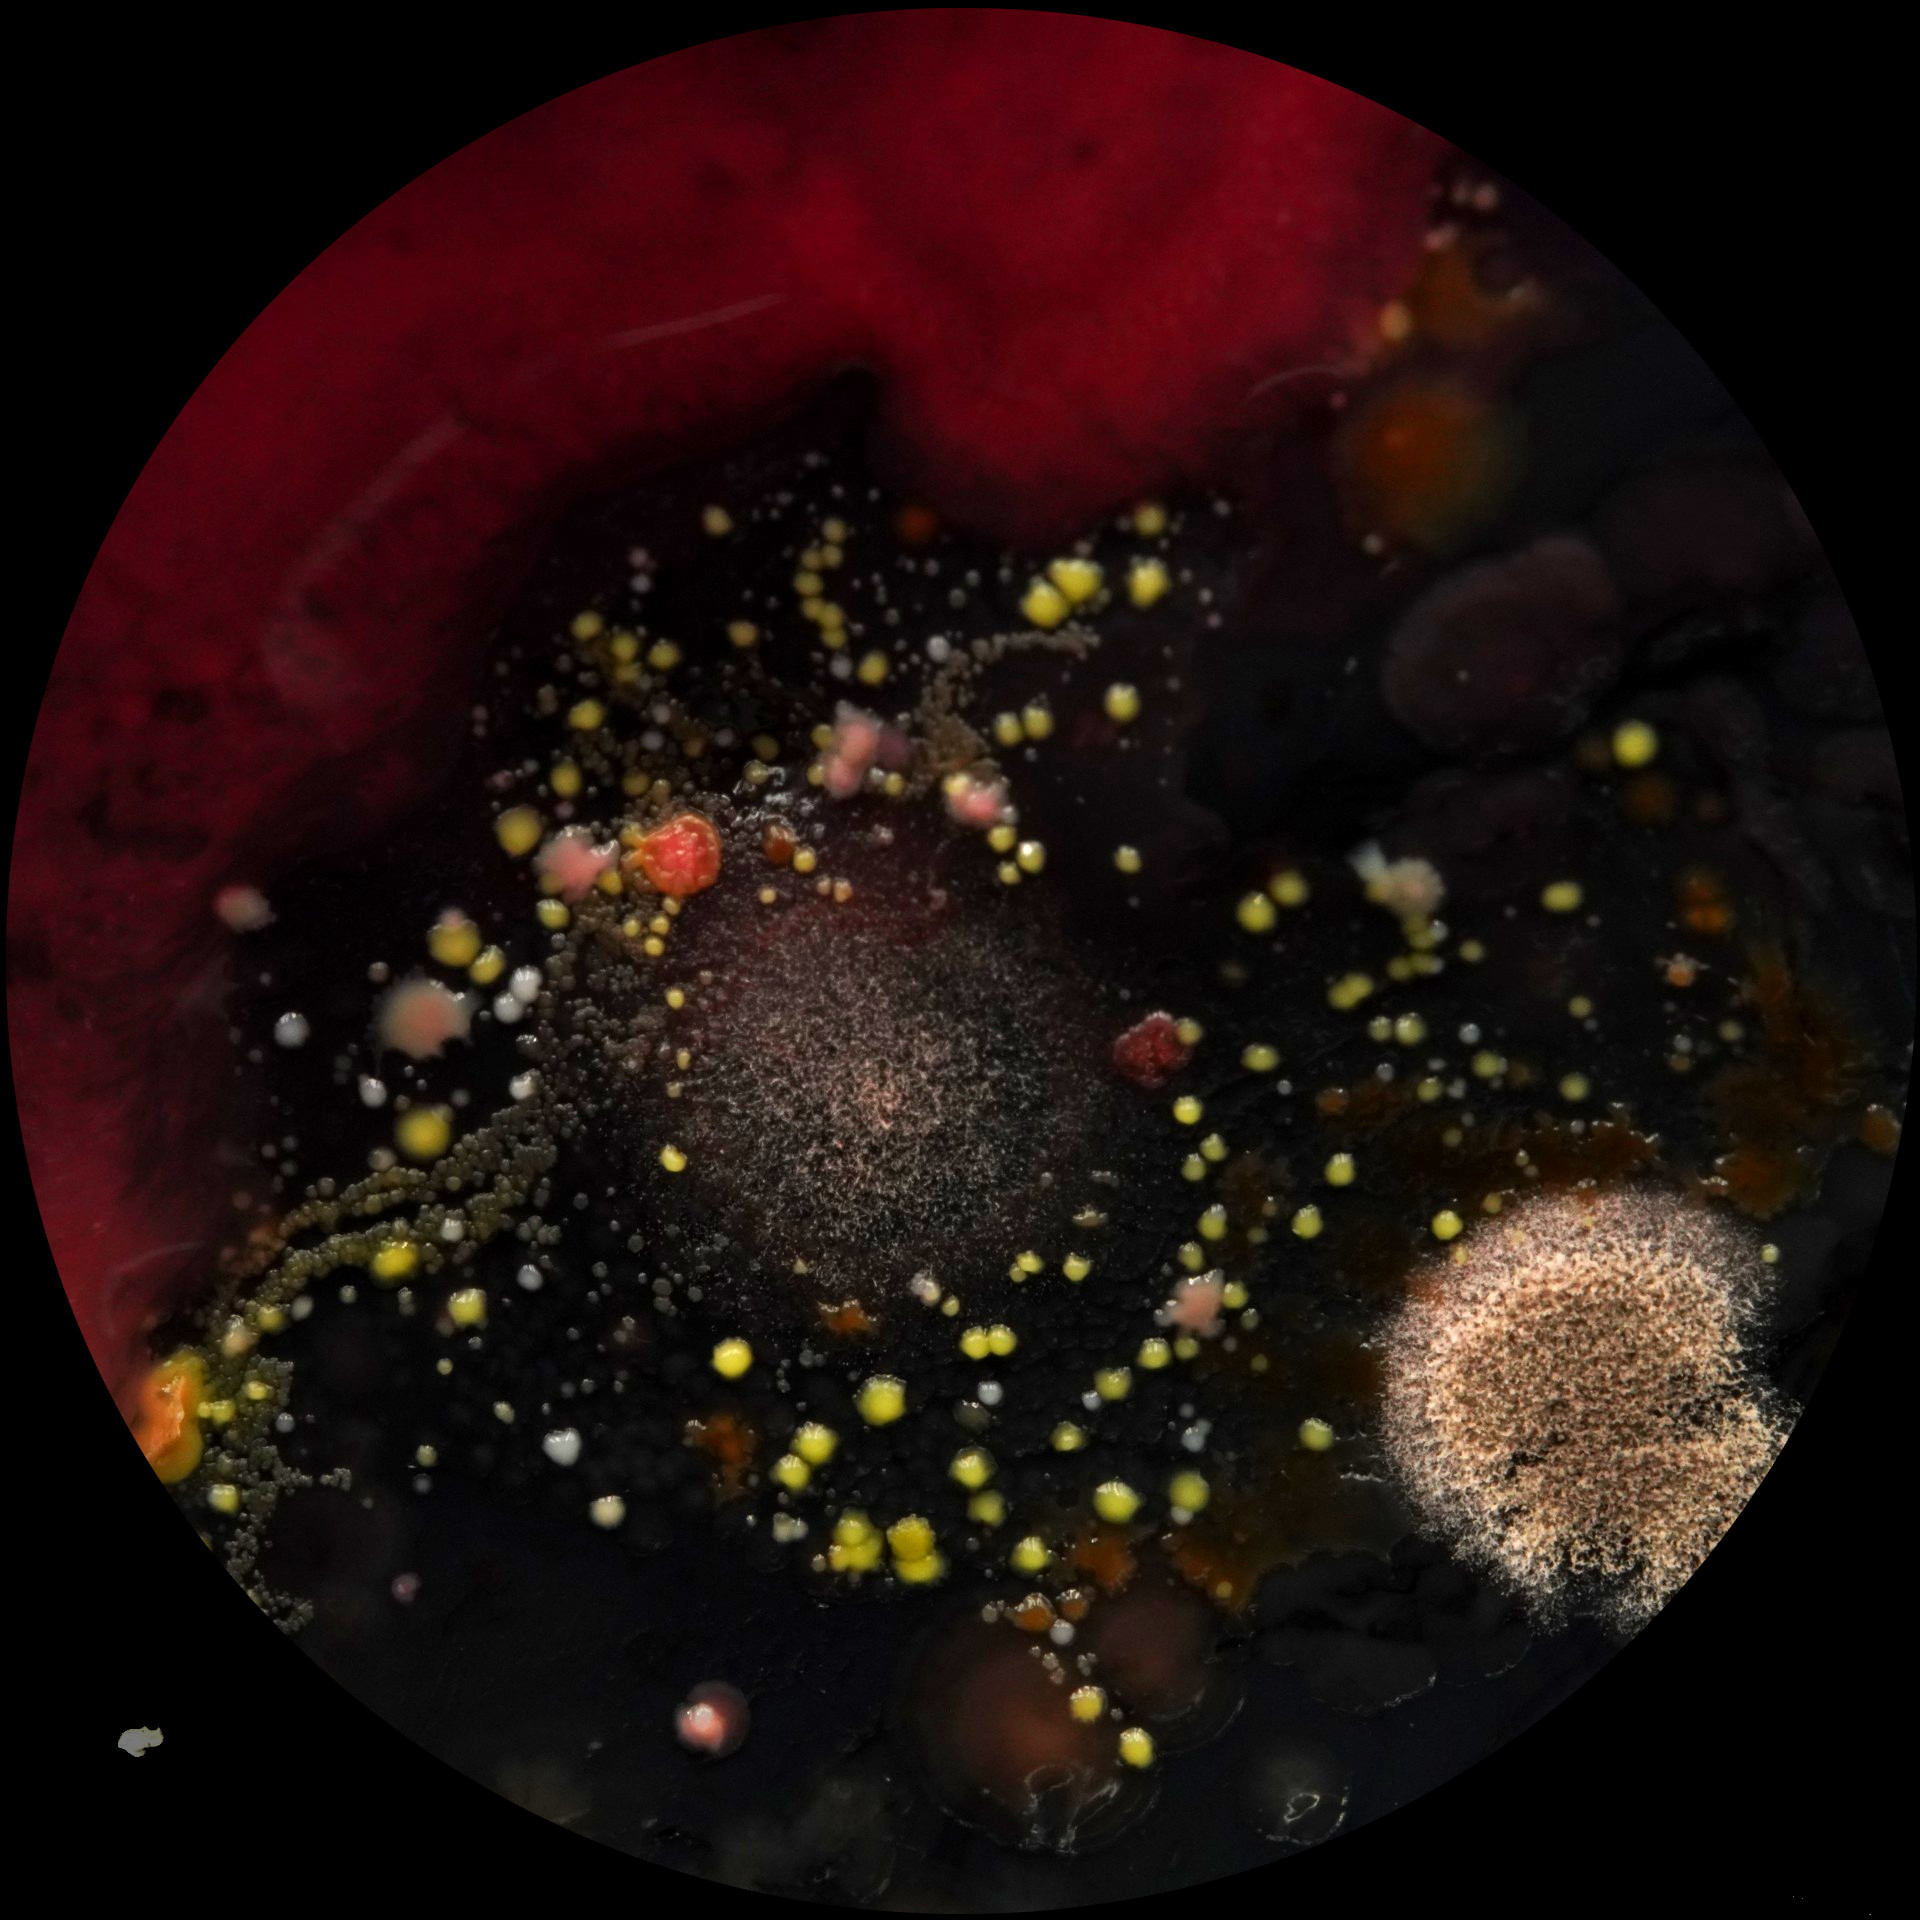

Domo Lleno Idartes
Miércoles 23 y Sábado 25 | 7:00 p.m. Domo YAWA. Centro de Ciencia, Arte y Tecnología de Cali

El Festival Domo Lleno, de la Línea de Arte, Ciencia y Tecnología desde 2017 se ha consolidado como el primer festival de Domo en Colombia y como un referente en América Latina, que impulsa y fomenta la exploración, investigación y experimentación audiovisual y sonora en formatos fulldome, para visibilizar el trabajo de artistas emergentes y consolidados tanto en la escena local, como internacional, destacando desde hace un par de años también las posibilidades de lo interactivo y transmedial. www.domolleno.gov.co
En el marco de FICCALI se exhiben los 4 proyectos seleccionados de la Beca Videoarte para Domo de la Línea de Arte, Ciencia y Tecnología del Idartes, que se oferta por medio del portafolio Distrital de Estímulos. La cual promueve la creación de proyectos audiovisuales, sonoros o interactivos en formato fulldome, con un enfoque especial en experiencias inmersivas. Esta convocatoria está dirigida a creadores audiovisuales, artistas sonoros, multidisciplinarios, mediales o videoartistas que exploren el uso de tecnologías audiovisuales, sonoras, expandidas e interactivas.
Para la edición de este año de FICCALI, desde la Línea de Arte, Ciencia y Tecnología del Instituto Distrital de las Artes-Idartes, se propone una curaduría de obras, que recoge obras ganadoras de distintas ediciones de la Beca Videoarte para Domo.
Dinámicas de un Ambiente en Crisis

- Autor: Juan Franco
- Duración: 9 min
- País: Colombia
Sinopsis
Dinámicas de un ambiente en crisis es una experiencia audiovisual Fulldome que combina arte, ciencia y tecnología para narrar el impacto humano en la emergencia de fenómenos naturales extremos, utilizando visualización de datos, escaneo 3D, simulaciones y generación de sonido e imagen mediante inteligencia artificial.
Proyecto ganador de la Beca Videoarte para Domo de la Línea de Arte, Ciencia y Tecnología del Idartes. Presentado en el Festival Domo Lleno
www.domolleno.gov.co
Reseña director(a)
Juan Franco es maestro en artes visuales con énfasis audiovisual, centra su interés en la experimentación con imagen y sonido para crear contenidos en diversos formatos digitales que generen experiencias inmersivas e interactivas, enfocadas en temáticas relacionadas con comunidades, procesos sociales y naturales. Ha dirigido proyectos audiovisuales e interactivos para instituciones como la Universidad de York en Reino Unido, Platzi y la Comisión Colombiana del Océano (CCO). En 2021 fue ganador de la Beca de Creación de Video Arte para Domo y actualmente se desempeña como Co-Director de Altano Project, un colectivo dedicado a la creación de contenidos audiovisuales e interactivos que conectan arte y ciencia.
AnimalArk

- Autor: MOAT
- Duración: 6 min
- País: Colombia
Sinopsis
AnimalArk es una obra que nace de la tensión constante entre la preservación de la biodiversidad en Colombia y las necesidades humanas que impulsan la explotación de los ecosistemas. Colombia, rica en fauna y flora, enfrenta un proceso de desplazamiento y reducción de sus hábitats naturales debido a la extracción y consumo, afectando directamente a especies en estado crítico de vulnerabilidad. Esta obra se presenta como una experiencia contemplativa en formato expandido, donde la animación es el eje central para crear atmósferas que resalten la belleza de estas especies en contraposición con la destrucción causada por las acciones humanas. El proyecto se apoya en modelos informáticos, recursos multimedia y bibliografía especializada para dar forma a una narrativa que invita a la reflexión sobre la relación entre especies, y que enfatiza la urgencia de transformar ese vínculo.
Proyecto ganador de la Beca Videoarte para Domo de la Línea de Arte, Ciencia y Tecnología del Idartes. Presentado en el Festival Domo Lleno
www.Domolleno.gov.co
Proyecto ganador de la Beca Videoarte para Domo de la Línea de Arte, Ciencia y Tecnología del Idartes. Presentado en el Festival Domo Lleno
www.domolleno.gov.co
Reseña Director(a)
El colectivo MOAT, creador de AnimalArk, se especializa en proyectos audiovisuales que exploran nuevas formas de contar historias mediante la animación, ilustración, diseño gráfico y tecnologías innovadoras. Creen en el poder transformador de las ideas y buscan generar mensajes que inviten a la reflexión y el cambio. MOAT combina ciencia, arte y tecnología para crear narrativas híbridas, integrando técnicas análogas y digitales en formatos expandidos, todo ello basado en datos y hechos reales.
MICROuniversos
- Autor: Hamilton Mestizo
- Duración: 26 min
- País: Colombia
Sinopsis
¿En qué momento se presenta el fenómeno de la vida en el universo? ¿Su memoria y formación serán tan antiguas como la creación de la materia en sí misma? La vida microscópica se presenta como evidencia de la complejidad del universo, evoluciona en infinitas formas, patrones de crecimiento, interacciones entre distintas especies y reinos, colores, texturas y movimientos, los cuales se pueden comparar con galaxias, constelaciones, planetas, mundos y MICROuniversos que evolucionan en el aire de nuestro planeta. Esta película explora estas consonancias visuales entre estos organismos y el cosmos a través de la microbiología y la fotografía microscópica en una experiencia audiovisual que documenta el crecimiento de microorganismos del aire colectados en distintos ambientes.
Proyecto ganador de la Beca Videoarte para Domo de la Línea de Arte, Ciencia y Tecnología del Idartes. Presentado en el Festival Domo Lleno
www.domolleno.gov.co
Reseña Director(a)
Hamilton Mestizo es doctor en Bellas Artes por la Universidad Complutense de Madrid (2023). Su línea de investigación hace énfasis en la creación y experimentación trans-disciplinar, articulando arte, diseño, ciencia y tecnología desde una perspectiva crítica, estudiando su impacto social, cultural y/o ecológico.
Desconexión

- Autor: Jorge Bandera
- Duración: 10 min
- País: Colombia
Sinopsis
Desconexión (2018) es una obra audiovisual para domo que nace como reflexión a la desconexión evidente y axiomática con la humanidad. La obra gira en torno al momento de deterioro social en que nos encontramos.Estamos atrapados por defecto en una lógica de consumo, pero siempre en función del bienestar propio. La sociedad se encuentra en un momento en el que prima el individualismo, por encima de lo colectivo, y en este lugar es donde la obra se sustenta; generar reflexión e invitar a reconstruir esos lazos con la humanidad, con lo elemental, con la vida.
Proyecto ganador de la Beca Videoarte para Domo de la Línea de Arte, Ciencia y Tecnología del Idartes. Presentado en el Festival Domo Lleno
www.domolleno.gov.co
Reseña Director(a)
Jorge Bandera es diseñador, artista y docente, fusiona en su experiencia la intersección de los ámbitos laborales y académicos, explorando constantemente la relación entre la teoría y la práctica. Su enfoque interdisciplinario se manifiesta en una sólida trayectoria que abarca desde la creación de espacios artificiales hasta el desarrollo de artefactos digitales. Investiga la interconexión entre el arte y la ciencia, la producción de imágenes inmersivas, la realidad extendida, las instalaciones interactivas y la experimentación con formatos expandidos.
Del Ascenso a la Tierra Oscura

- Autor: Colectivo Ser Otro
- Duración: 9 min
- País: Colombia
Sinopsis
En los páramos los musgos y líquenes crecen sobre las superficies rocosas y las ablandan. Del Ascenso a la Tierra Oscura (2021) nos lleva en un viaje inmersivo a través de este proceso vital de construcción del suelo paramuno. Distintas capas de texturas audiovisuales se superponen, construyen y descomponen en ciclos de vida y muerte.
Proyecto ganador de la Beca Videoarte para Domo de la Línea de Arte, Ciencia y Tecnología del Idartes. Presentado en el Festival Domo Lleno
www.domolleno.gov.co
Reseña Director(a)
Colectivo Ser Otro es un colectivo de artistas que investiga y crea en la convergencia entre arte, ciencia y tecnología. Partimos de un interés por explorar y replantear las relaciones que establecemos los seres humanos con los no-humanos y el entorno que cohabitamos. A partir de un lenguaje material y simbólico, proponemos experiencias poéticas en las que interactúan diversos medios plásticos y audiovisuales.